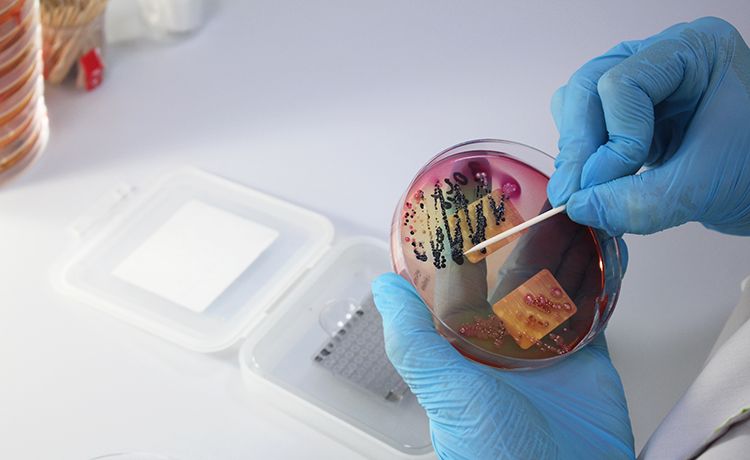

Дисбактериоз кишечника: Микробиологические исследования и графики

.jpg)







Раздел: Фотомир